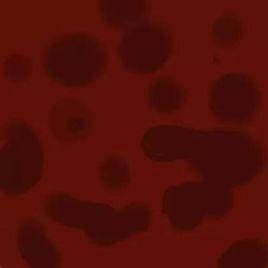
血性惡露 血性惡露

原因
當胎兒娩出後的3-4周內,子宮腔內的組織物、粘液和創面排出的血液混合在一起,從陰道內排出,俗稱惡露。
在中醫典籍《胎產心法》中提到:由於產時傷其經血,虛損不足,不能收攝,或惡血不盡,則好血難安,相併而下,日久不止。因此,惡露不止多與虛損或血瘀有關。正常惡露有血腥味,但無臭味,持續4到6周,總量約250ml-500ml,個體差異較大。產後第一周,惡露的量較多,顏色鮮紅,含有大量的血液、小血塊和壞死的蛻膜組織,稱為紅色惡露。1周以後至半個月內,惡露中的血液量減少,較多的是壞死的蛻膜、宮頸黏液、陰道分泌物及細菌,使得惡露變為淺紅色的漿液,此時的惡露稱為漿性惡露。中醫認為產後傷其經血,虛損不足,不能收攝,或惡血不盡,則好血難安,相併而下,日久不止。
女性產後惡露不淨的原因大致上與身體虛弱有關,多為氣虛血瘀或血熱。氣虛的婦女產前本身血氣不足,加上分娩時失血產後也沒有好好調理進補,以致操勞傷脾傷氣不能攝血,血瘀者惡露瘀結以致血行不暢;血熱的婦女因分娩時失血陰虛則血熱迫熱妄行。
檢查
觀察一下你的惡露情況是否正常。有些惡露屬於異常情況,應當引起注意
分娩後兩天來,陰道里仍然淋漓不盡,不斷有些像血水一樣的液體流出來。醫生說,那是惡露,是正常現象。但是,看到那些鮮紅色的黏液,中間還混有血塊,產後,隨著子宮內膜(特別是胎盤附著地方的內膜)脫落,子宮分泌的黏液等也隨之從陰道內流出,這就是惡露。正常的惡露有些血腥味,但是不臭,總量大約為500~1000毫升。一般情況下,惡露大約在產後3周左右就乾淨了。
產後第一周,惡露的量較多,顏色鮮紅,含有大量的血液、小血塊和壞死的蛻膜組織,稱為紅色惡露。
鑑別診斷
血性惡露易混淆的症狀
血性惡露持續時間延長:子宮復舊不全最突出的臨床表現是血性惡露持續時間延長,從正常的僅持續3天,延長至7~10天,甚至更長。若病因為胎盤殘留,則血性惡露持續時間長,而且血量也明顯增多,此時惡露常渾濁或伴有臭味。
產褥期惡露:產婦分娩後隨子宮蛻膜特別是胎盤附著物處蛻膜的脫落,含有血液,壞死蛻膜等組織經陰道排出稱為惡露。產後惡露持續三周以上仍淋瀝不斷者,稱為產後惡露不絕。產後惡露不絕是由於產時勞傷經脈,導致氣血運行失常,而致產後3周以上,仍有陰道出血者。相當於子宮復舊不良,子宮輕度感染,胎盤、胎膜殘留。正常情況下,產後3周左右惡露即淨,若超過3周惡露仍不淨,則為病理現象。量或多或少,色或淡紅或深紅或紫暗,或有血塊,或有臭味或無臭味;產婦常伴有腰酸痛、下腹墜脹疼痛,有時可發熱、頭痛、關節酸痛等,婦科檢查可發現子宮復舊不良。
白色惡露:粘稠,色澤較白。含大量白細胞,壞死組織蛻膜,表皮細胞及細菌等。白色惡露持續3周乾淨。
產後惡露不淨有臭味:晚期產後出血多表現為產後惡露不淨有臭味,反覆或突然陰道大出血可導致貧血、休克甚至危及生命。晚期產後出血指分娩24h後,在產褥期內發生的子宮大量出血,出血量超過500ml。產後1~2周發病最常見亦有遲至產後6周發病。又稱產褥期出血。晚期產後出血發生率的高低與各地產前保健及產科質量水平密切相關。有下腹痛、低熱或產後低熱史。
緩解方法
1.惡露如有異常情況及時請醫生進行診治,同時也要注意產後衛生,如常更換會陰墊、每天換一條內褲、預防生殖道感染。
2.正常分娩的新媽咪如果健康狀況良好,在產後24小時便可以下床活動,促進惡露排出。
3.在醫生指導下做產褥操,喝一些紅糖水活血化淤,也可以促進惡露順暢排出,有利於子宮縮復。
4.產婦在睡眠時最好採取側臥的姿勢,以免子宮向後傾倒而不利於惡露排出、排淨。